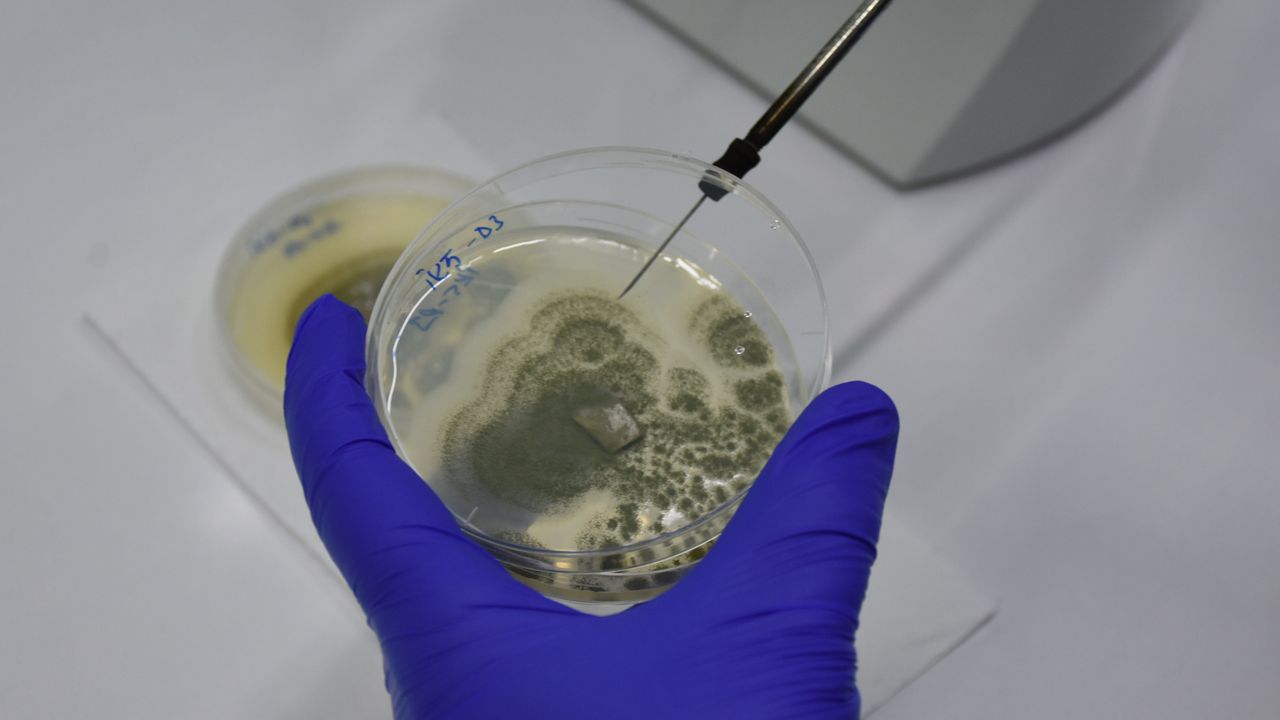

İnönü Üniversitesi Gıda Mühendisliği Bölümü Öğretim Üyesi ve proje yürütücüsü Prof. Dr. Murat Yılmaztekin, TÜBİTAK BiGG Yatırım desteğiyle 1,5 yıl önce başladığı proje kapsamında gıdalarda oluşan zararlı toksinlerin belirlenmesinde kullanılan sıvı ve toz analitik standart maddeleri üretti.
Tamamı yurt dışından ithal edilen, gıdalarda küf ve mantarların oluşturduğu zehirli bileşikleri belirlemede ve ölçmede kullanılan maddeler için "Analitik aflatoksin standart maddesi üretim yöntemi" başlığıyla patent alındı.
Prof. Dr. Murat Yılmaztekin, AA muhabirine, gıda biyoteknolojisi konusunda araştırmalar yaptığını, gıda analizlerinde kullanılan maddelerin üretilmesi için 1,5 yıldır Malatya Teknokent'te çalışma yaptıklarını söyledi.
Mikotoksinlerin sağlığa zararlı olduğunun altını çizen Yılmaztekin, şöyle konuştu:
"İnsan ve hayvan sağlığı açısından son derece riskli oldukları için uluslararası mevzuatlar ve Türk Gıda Kodeksi bu bileşiklerin izlenmesini zorunlu kıldı. Mikotoksinlerin cihazlarda doğru ölçümlerinin yapılmasını sağlayan referans maddeler var. Küresel pazara baktığımızda mikotoksinlerin ölçümünde kullanılan bu referans maddelerin 2023'te yaklaşık 1,2 milyar dolarlık pazarı vardı. 2033 yılına kadar bu rakamın 2,5 milyar dolara çıkması bekleniyor. Türkiye'de ise kamu ve özel 150 laboratuvarda yılda yaklaşık 1 milyon gıda ve yem numunesinde mikotoksin analizi yapılıyor. Gıda analizlerinde kullanılan bu maddelerin tamamı ithal edilmekte ve yılda yaklaşık 45 milyon dolarlık maliyeti var. Dışa bağımlılığı azaltmak, yerli ve güvenilir üretim altyapısı kurmak için çalışıyoruz."
Kullanıma hazır hale getirildi
TÜBİTAK BiGG tohum öncesi yatırım desteği ile doktora danışmanlığını yaptığı Doktor Öğretim Üyesi Hüseyin Karakaya ile yürüttükleri AR-GE projesinin olumlu sonuçlandığını ifade eden Yılmaztekin, çalışmanın Türk Patent ve Marka Kurumundan "Analitik aflatoksin standart maddesi üretim yöntemi" başlığıyla patentini aldıklarını söyledi.
Yılmaztekin, şöyle devam etti:
"Gıda analizlerinde kullanılan standart maddeleri laboratuvarda başarılı şekilde üreterek kullanıma hazır hale getirdik. Sertifikasyon aşamalarından sonra mikotoksin analizlerinde laboratuvarlarda kullanılabilecek. Bir üretimde 300 ila 500 standartlık kapasite oluşturmamız mümkün. Yapacağımız üretim Türkiye'nin ihtiyacının tamamın karşılayacak düzeyde. AR-GE çalışmalarıyla gıda analizlerinde kullanılan analitik standart maddeleri yüksek saflıkta üretmeyi başardık ve kullanıma hazır hale getirdik. Sertifikasyon aşamasının tamamlanmasının ardından piyasada kullanılabilecek. Bu patent, ülkemizde bu alanda alınan ilk özgün üretim teknolojilerinden birini temsil ediyor. Ürünümüz kullanıma hazır, elimizde şu an 300 standart maddelik stokumuz var, sertifika aşamalarını tamamladıktan sonra piyasaya süreceğiz. TÜBİTAK'tan alacağımız destekle üretim hattımızı yenileyeceğiz, gerekli cihazların alımını gerçekleştirdikten sonra seri üretime başlayacağız."
Malatya Teknokent Genel Müdürü Doç. Dr. Hasan Yılmaz ise yerli üretimi önemsediklerini ifade etti.
Sanayi ve Teknoloji Bakanlığının üretilen madde için Teknogirişim Rozeti verdiğini dile getiren Yılmaz,
"Bu rozet yenilik odaklı, sürdürülebilir ve ölçeklenebilir AR-GE projelerine Bakanlığın verdiği belge. Teknokent adına mutluyuz, gururluyuz. Kurum olarak AR-GE projelerine destek veriyoruz."
dedi.